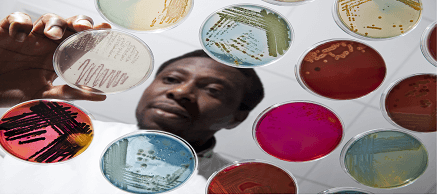
Biology.png

취업 잘 되는 미국 STEM 리스트
"이 전공하면 미국에서 취업 가능성 높다"
대학 명성보다 전공이 더 중요할 수도
STEM 분야로 알려져 있는 과학, 기술, 공학, 수학은 오늘날 세계 사회의 필수적인 요소들이다. STEM이 없다면 생명을 구하고, 경제를 개선하고, 생산성을 증가시키기 위한 발전이나 발견은 거의 없을 것이다.
다행히 전 세계 대학들은 인력 수요에 대응하여 STEM 전공자가 늘어나고 있다. 이러한 학사 과정 프로그램은 전형적으로 학생들이 실제 상황에 원칙을 적용하도록 하기 위해 실제 활동과 프로젝트 기반 학습을 제공한다.
과학, 기술, 공학 또는 수학 관련 초점과 함께 학위 프로그램을 완성하면 팀워크와 사려 깊은 대화를 통해 다른 사람들과 아이디어를 교환하는 보다 창의적이고 비판적인 사고를 할 수 있다. STEM 학위를 취득한 후, 졸업생들은 문제 해결과 새로운 지식 창출과 관련된 직업을 기대할 수 있다.
STEM 전공 가운데 미국에서 가장 유망한 전공 몇개를 선정해 보았다.
STEM 전공 전체 리스트를 보려면 다음을 클릭하면 된다.
https://www.ice.gov/sites/default/files/documents/Document/2016/stem-list.pdf
주요 STEM 전공 리스트

Of all the STEM majors analyzed, petroleum engineering rose to the top spot on this year's ranking, an increase in its position over previous years. Petroleum engineering programs teach students how to address and solve crucial problems that can lead to energy security. By pursuing a bachelor's degree program in petroleum engineering, you can learn how to evaluate potential oil and gas reservoirs, oversee drilling activities, and design surface collection and treatment facilities. Since many petroleum companies operate around the world, this major can give you the opportunity to travel and solve various technological, political, and economic issues in different countries.
Category Rankings
Educational Availability:No. 90
Educational Affordability:No. 47
Earning Potential:No. 1
Employment Opportunity:No. 32
Spotlight Career: Petroleum Engineer
Average Salary, 2017: $154,780
Projected Growth Rate, 2016-26: 14.5%
Average Annual Job Openings, 2016-26: 2,800

This degree program makes its first appearance on our "best STEM majors" list, as more schools have begun to offer it. Students who major in atomic or molecular physics investigate the structure and behavior of atoms and molecules. They spend their time studying a variety of subjects including atomic forces, molecular bonding, and the quantum theory of solids. When you graduate with a bachelor's degree in atomic or molecular physics, you're likely to land a job in research or teaching or you can pursue a position at a government agency or national laboratory where you can question, observe, and create models and theories to further understand various sciences and modern technology.
Category Rankings
Educational Availability:No. 208
Educational Affordability:No. 4
Earning Potential:No. 4
Employment Opportunity:No. 65
Spotlight Career: Natural Sciences Manger
Average Salary, 2017: $133,670
Projected Growth Rate, 2016-26: 9.9%
Average Annual Job Openings, 2016-26: 5,200

In a management science degree program, students focus on the design and administration of complex systems. They learn how to use quantitative tools and qualitative methods to explore a wide array of strategic and logistical problems. With a bachelor's degree in management science, you can help organizations save time, money, and resources. Fields like engineering, computer science, marketing, economics, and logistics could all benefit from employees who have completed a bachelor's degree in management science. This is one of the STEM degrees that brings with it a fair amount of flexibility in terms of working in a variety of industries.
Category Rankings
Educational Availability:No. 34
Educational Affordability:No. 145
Earning Potential:No. 3
Employment Opportunity:No. 7
Spotlight Career: Operations Research Analyst
Average Salary, 2017: $86,510
Projected Growth Rate, 2016-26: 27.4%
Average Annual Job Openings, 2016-26: 10,700

Since information drives our economy, nearly every industry is in need of qualified information technology or IT professionals, making it one of the best STEM majors in regards to employment opportunities. Students who earn bachelor's degrees in information technology can prepare themselves for positions such as computer system analysts, network engineers, computer programmers, software or web developers, and IT managers. If you pursue a degree in IT, you can expect to take core courses such as IT applications, IT foundations, networks, cloud foundations, Linux foundations, emerging technologies, and data management.
Category Rankings
Educational Availability:No. 13
Educational Affordability:No. 87
Earning Potential:No. 97
Employment Opportunity:No. 6
Spotlight Career: Computer Systems Analyst
Average Salary, 2017: $106,710
Projected Growth Rate, 2016-26: 30.5%
Average Annual Job Openings, 2016-26: 85,500

The increase in water resources engineering programs has earned this major its first appearance on this list. Water resources engineering is a type of civil engineering that involves designing new systems and equipment to help manage water for industrial, recreational, agricultural, household, or environmental purposes. Examples of courses for this major include groundwater hydrology, hydraulic design, hazardous waste treatment, and lab work in hydraulic engineering. By completing a water resources engineering degree, you can become well-versed in both civil and agricultural engineering principles — preparing you for a career as an environmental resource specialist, hydrogeologist, research hydraulic engineer, water resources engineer, or national stormwater leader.
Category Rankings
Educational Availability:No. 194
Educational Affordability:No. 2
Earning Potential:No. 64
Employment Opportunity:No. 54
Spotlight Career: Civil Engineer
Average Salary, 2017: $91,790
Projected Growth Rate, 2016-26: 10.6%
Average Annual Job Openings, 2016-26: 25,900

Computer engineering is mainly concerned with the creation of devices and systems that process information. After graduating with a bachelor's degree in computer engineering, you may land a position as a computer network architect in an industry such as aerospace, automotive, electronics, communications, healthcare, robotics, or transportation. In the workplace you can expect to need to keep up to speed with the latest software systems. With the expansion of computers into all aspects of everyday life, computer engineers are known as the driving force behind most of the new technologies in today's world.
Category Rankings
Educational Availability:No. 15
Educational Affordability:No. 110
Earning Potential:No. 69
Employment Opportunity:No. 15
Spotlight Career: Computer Network Architect
Average Salary, 2017: $111,780
Projected Growth Rate, 2016-26: 10.8%
Average Annual Job Openings, 2016-26: 32,700

The main goal of an information science or studies degree program is to educate students on how to understand and define problems and use technology to resolve them. Information science or studies programs typically include courses such as software design and development, algorithms and data structures, and ethical issues in computing. Having a bachelor's degree in information science or studies can give you the opportunity leverage your newly learned skills as a computer or information systems manager, data analyst, knowledge manner, or systems analyst.
Category Rankings
Educational Availability:No. 16
Educational Affordability:No. 100
Earning Potential:No. 71
Employment Opportunity:No. 19
Spotlight Career: Computer and Information Systems Manager
Average Salary, 2015: $149,730
Projected Growth Rate, 2016-26: 11.9%
Average Annual Job Openings, 2016-26: 32,500

Students who major in biology or biological sciences can receive a solid foundation on molecules, ecosystems, and all levels of biological organization. They may take courses like cellular biology, ecology, genetics, zoology, and botany. As the holder of an undergraduate degree in biology or biological sciences, you'll be able to explain the importance of biological concepts and can pursue a career as a biological scientist or biologists. These professionals often specialize in a field like zoology or microbiology and study living organisms such as plants, animals, and bacteria.
Category Rankings
Educational Availability:No. 1
Educational Affordability:No. 136
Earning Potential:No. 181
Employment Opportunity:No. 38
Spotlight Career: Biological Scientist
Average Salary, 2017: $80,200
Projected Growth Rate, 2016-26: 7.9%
Average Annual Job Openings, 2016-26: 3,700

Another one of the best STEM degrees — and another newcomer to this list — is in the field of chemical engineering. This versatile field can allow students to gain the knowledge and skills necessary to work in industries such as healthcare, pharmaceuticals, construction, manufacturing, biotechnology, and environmental health and safety. If you enroll in a chemical engineering bachelor's degree program, you can expect to take courses in chemistry, physics, and general engineering. These courses can provide you with the information you need to solve problems that involve the production or use of chemicals so you can help improve the environment and efficiency of energy conversion.
Category Rankings
Educational Availability:No. 208
Educational Affordability:No. 7
Earning Potential:No. 25
Employment Opportunity:No. 120
Spotlight Career: Chemical Engineer
Average Salary, 2017: $112,430
Projected Growth Rate, 2016-26: 7.6%
Average Annual Job Openings, 2016-26: 2,400
Microbiological Sciences and Immunology

A four-year degree in microbiological sciences and immunology may be a good option for students who are interested in studying infectious diseases and would like to be involved in conducting clinical trials for new drugs. This program involves courses like infectious disease, medical microbiology, immunology, and other courses focused on the interaction between microorganisms and human disease. By completing a microbiological and immunology degree, you can enjoy a career at a medical corporation, biological testing laboratory, pharmaceutical company, or government agency. This program also makes its debut on WorldWideLearn's "best STEM majors" list.
Category Rankings
Educational Availability:No. 208
Educational Affordability:No. 51
Earning Potential:No. 4
Employment Opportunity:No. 65
Spotlight Career: Natural Sciences Manager
Average Salary, 2017: $133,670
Projected Growth Rate, 2016-26: 9.9%
Average Annual Job Openings, 2016-26: 5,200
Network and System Administration

When computer networks are malfunctioning, professionals with a network and system administration degree can come to the rescue. A network and system administration degree program can teach you how to keep computer networks and technology running efficiently so that you could support a variety of organizations. Earning a bachelor's degree in network and system administration can prepare you to pursue a challenging yet rewarding career as an information security analyst, network support engineer, local area administrator, or network technician. The prevalence of technology in our day-to-day lives lends extra weight to the importance of those in this occupation.
Category Rankings
Educational Availability:No. 57
Educational Affordability:No. 56
Earning Potential:No. 98
Employment Opportunity:No. 16
Spotlight Career: Information Security Analyst
Average Salary, 2017: $99,690
Projected Growth Rate, 2016-26: 28.4%
Average Annual Job Openings, 2016-26: 10,400

Students seeking careers in research, teaching, the sciences, business, or government may all benefit from a bachelor's degree program in mathematics. If you decide to major in mathematics, you're likely to have the opportunity to explore advanced mathematical theory and analytical methods while sharpening your critical-thinking skills. You can also expect to take courses such as calculus, trigonometry, technical writing, probability theory with applications, and mathematical modeling. Once you graduate, you can apply mathematics to investigate and solve problems in a variety of fields or use use mathematical models to provide insights into complex issues for different industries.
Category Rankings
Educational Availability:No. 2
Educational Affordability:No. 150
Earning Potential:No. 163
Employment Opportunity:No. 33
Spotlight Career: Secondary School Teacher
Average Salary, 2017: $62,860
Projected Growth Rate, 2016-26: 7.5%
Average Annual Job Openings, 2016-26: 79,500

Bachelor's degree programs in computer science are designed to provide students with instruction in the latest software engineering methods and practices. With a computer science degree, you can pair a solid mathematical background with the ability to design and develop software. You may choose to become a software developer, IT consultant, database administrator, games developer, technical writer, or cybersecurity consultant. Since computer technologies play a vital role in virtually every aspect of modern life, computer science skills are in high demand across a wide range of industries.
Category Rankings
Educational Availability:No. 5
Educational Affordability:No. 157
Earning Potential:No. 111
Employment Opportunity:No. 10
Spotlight Career: Software Developer, Systems Software
Average Salary, 2017: $111,780
Projected Growth Rate, 2016-26: 10.8%
Average Annual Job Openings, 2016-26: 32,700

While many of the best STEM majors focus on cutting-edge technologies, this brand-new addition to our list focuses on understanding the past. A four-year degree program in paleontology can train students how to discover the secrets of ancient plant life and dinosaur bones. It may also provide the opportunity to participate in research projects with curators at museums and develop valuable hands-on experience. If you decide to pursue a paleontology degree, you can expect to take courses such as introductory zoology, paleobotany, structural geology, geowriting, and invertebrate paleontology. Following graduation, you may enjoy a career as a geologist, researcher, curator, topographic surveyor, or anthropologist.
Category Rankings
Educational Availability:No. 208
Educational Affordability:No. 36
Earning Potential:No. 55
Employment Opportunity:No. 61
Spotlight Career: Geoscientist
Average Salary, 2017: $105,830
Projected Growth Rate, 2016-26: 13.9%
Average Annual Job Openings, 2016-26: 3,500

Bachelor's degree programs in software engineering are designed to help students analyze user needs, design software, deploy it, test it for quality, and maintain it. If you're intrigued by the idea of designing business applications, computer games, software operating systems, and network control systems, consider majoring in computer software engineering. A bachelor's degree in computer software engineering can set you up for a career as a software engineer, architectural and engineering manager, video game designer, cybersecurity manager, or sales engineer.
Category Rankings
Educational Availability:No. 44
Educational Affordability:No. 134
Earning Potential:No. 53
Employment Opportunity:No. 5
Spotlight Career: Architectural and Engineering Manager
Average Salary, 2017: $146,290
Projected Growth Rate, 2016-26: 5.5%
Average Annual Job Openings, 2016-26: 13,600

The study, design, and development of information technology for the good of people, organizations, and society is known as informatics. If you have a passion for driving innovation, a bachelor's degree in informatics may be right for you. By pursuing this type of degree, you can learn how to design effective and easy-to-use interfaces and develop robust and scalable technology. After graduation, you may land a fulfilling career as a software developer, product planner, data scientist, user experience designer, or information architect. Of all 232 STEM majors reviewed for this ranking, informatics was no. 1 in terms of employment opportunities.
Category Rankings
Educational Availability:No. 95
Educational Affordability:No. 91
Earning Potential:No. 101
Employment Opportunity:No. 1
Spotlight Career: Software Developers, Applications
Average Salary, 2017: $106,710
Projected Growth Rate, 2016-26: 30.5%
Average Annual Job Openings, 2016-26: 85,500
Mining and Mineral Engineering

An undergraduate degree program in mining and mineral engineering is intended to prepare students to pursue careers in exploring, planning, extracting, and processing minerals — valuable resources than can have direct or indirect impact on our everyday lives. While most students who choose this major become mining engineers, some work as mine managers, mine planning engineers, or consulting engineers. If you enroll in a mining and mineral engineering degree program, you can expect to take courses related to mine ventilation, environmental law and labor management, mine operation, and ground control.
Category Rankings
Educational Availability:No. 110
Educational Affordability:No. 31
Earning Potential:No. 30
Employment Opportunity:No. 178
Spotlight Career: Mining and Geological Engineer
Average Salary, 2017: $103,710
Projected Growth Rate, 2016-26: 7.2%
Average Annual Job Openings, 2016-26: 600

Statistics gained its first spot on this list - not surprising, given the increase in data generated and collected in our tech-focused world. Statistics majors focus their education on theories and methods of data collection, tabulation, analysis, and interpretation. As more industries become data heavy, statistics graduates can land positions in a variety of organizations as actuaries, business analysts, biostatisticians, data analysts, and cost estimators. With a bachelor's degree in statistics, you can be involved in planning the market strategy at a small or large business, developing a new life-saving drug, shaping public policy in government, or managing investment portfolios in finance.
Category Rankings
Educational Availability:No. 139
Educational Affordability:No. 75
Earning Potential:No. 31
Employment Opportunity:No. 85
Spotlight Career: Actuary
Average Salary, 2017: $114,850
Projected Growth Rate, 2016-26: 22.5%
Average Annual Job Openings, 2016-26: 2,100
Geographic Information Science and Cartography

Geographic information science and cartography is a relatively new major, although this is its second appearance on our list. This major is designed to provides students with a strong technical background in geographic information systems, quantitative geographic analysis, and mapping technologies. By pursuing a bachelor's degree in geographic information science and cartography, you may work as a cartographer, photogrammetrist, remote sensing imagery analyst, project manager, or GIS educator. Some of the most common courses in undergraduate geographic information science and cartography degree programs include quantitative methods in geography, cartography, principles of remote sensing, and physical geology.
Category Rankings
Educational Availability:No. 73
Educational Affordability:No. 16
Earning Potential:No. 179
Employment Opportunity:No. 8
Spotlight Career: Cartographer and Photogrammetrist
Average Salary, 2017: $67,390
Projected Growth Rate, 2016-26: 19.4%
Average Annual Job Openings, 2016-26: 1,200

Do you enjoy math, computing, and the outdoors? If so, consider earning a bachelor's degree in one of the more outdoorsy STEM majors: surveying engineering. Surveying engineers use great precision to measure the physical features of the Earth. They establish land boundaries and play a vital role in the design and infrastructure of roads, bridges, and phone towers. Some students who complete a bachelor's degree program in surveying engineering take the Fundamentals of Surveying (FS) exam and become professional licensed surveyors. Others may pursue careers as cartographers, photogrammetrists, or field layout engineers.
Category Rankings
Educational Availability:No. 163
Educational Affordability:No. 21
Earning Potential:No. 37
Employment Opportunity:No. 166
Spotlight Career: Engineer
Average Salary, 2017: $99,310
Projected Growth Rate, 2016-26: 6.2%
Average Annual Job Openings, 2016-26: 9,500
Those who really enjoy being outdoors may want to pursue a major in forest engineering. Bachelor's degree programs in forest engineering aim to teach students how to implement complex forest and natural resource operations, blending the mechanic and economic requirements of forest operations with the biological requirements of the forest. If you are interested in learning how to use trees, soil, and water in an efficient, eco-friendly, and cost-effective manner, a four-year degree program in forest engineering may be ideal. It can allow you to work as a land use planner, forest technician, or researcher.
Category Rankings
Educational Availability:No. 208
Educational Affordability:No. 26
Earning Potential:No. 37
Employment Opportunity:No. 166
Spotlight Career: Architectural and Engineering Manager
Average Salary, 2017: $146,290
Projected Growth Rate, 2016-26: 5.5%
Average Annual Job Openings, 2016-26: 13,600
Students who pursue bachelor's degrees in paper science and engineering can gain access to engineering jobs in the paper or other chemical -process industries. They often pursue careers in manufacturing, management, and technical support in rural areas. In a paper science and engineering program, you can expect to take courses that focus on the principles of chemical engineering with specific content and examples related to the paper and pulp industry. You may also participate in a capstone course or internship, in which you acquire hands-on experience in paper-machine operations.
Category Rankings
Educational Availability:No. 194
Educational Affordability:No. 19
Earning Potential:No. 60
Employment Opportunity:No. 120
Spotlight Career: Chemical Engineer
Average Salary, 2017: $112,430
Projected Growth Rate, 2016-26: 7.6%
Average Annual Job Openings, 2016-26: 2,400

Biochemistry majors develop a strong background in biology and chemistry. If the idea of helping with medical research advances or working in agriculture or genetic engineering excites you, consider enrolling in an undergraduate biochemistry degree program. You can take courses related to biology, chemistry, genetics, and physics while participating in labs. Once you graduate, you may find employment as a biochemist, research and environmental scientist, lab manager, or scientific writer working in the chemical, medical, pharmaceutical, or cosmetic industry. Although other "bio" winners appear on this year's list of the best STEM degrees, this is biochemistry's first time.
Category Rankings
Educational Availability:No. 7
Educational Affordability:No. 181
Earning Potential:No. 4
Employment Opportunity:No. 65
Spotlight Career: Natural Sciences Manager
Average Salary, 2017: $113,670
Projected Growth Rate, 2016-26: 9.9%
Average Annual Job Openings, 2016-26: 5,200

Bachelor's degree programs in civil engineering are created to educate students on how to plan, analyze, design, and construct systems and structures like bridges, highways, canals, buildings, water supply systems, and transportation systems. In some programs, students can choose to specialize in areas such as construction management, geotechnical, transportation, or water resources. If you become a civil engineer, you are likely to split your time working in an office and outdoors at construction sites and may eventually earn licensure as a Professional Engineer.
Category Rankings
Educational Availability:No. 14
Educational Affordability:No. 104
Earning Potential:No. 64
Employment Opportunity:No. 54
Spotlight Career: Civil Engineer
Average Salary, 2017: $91,790
Projected Growth Rate, 2016-26: 1.6%
Average Annual Job Openings, 2016-26: 25,900
Biological and Physical Sciences

A bachelor's degree in biological and physical sciences is useful for students who are interested in the science of life and are seeking a broad education and foundation in biology principles. This degree program can prepare students to become natural science managers. Natural science managers are responsible for directing research and development projects by managing the work of chemists, physicists, biologists, and other scientists. As a biological and physical sciences student, you can expect to take courses such as molecular and cell biology, developmental biology, microbiology and immunology, and human biology.
Category Rankings
Educational Availability:No. 28
Educational Affordability:No. 119
Earning Potential:No. 4
Employment Opportunity:No. 65
Spotlight Career: Natural Sciences Manager
Average Salary, 2017: $113,670
Projected Growth Rate, 2016-26: 9.9%
Average Annual Job Openings, 2016-26: 5,200
